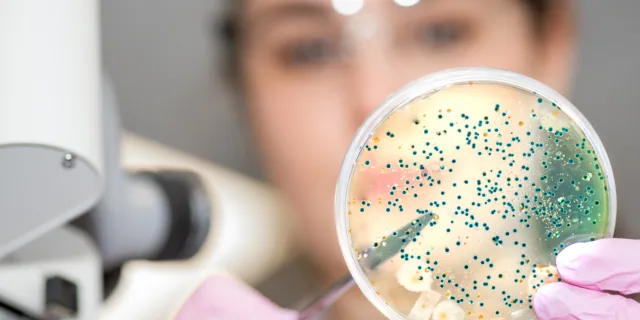

Industry Spotlight
Healthcare Supply Chain
Healthcare supply chains demand precision, security and continuous performance. Beacon Hill Technologies delivers consulting and technology solutions that modernize procurement, inventory, logistics and clinical distribution platforms while strengthening visibility, compliance and operational resilience.